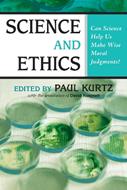

L’articolo è stato aggiunto alla lista dei desideri
IBS.it, l'altro eCommerce
Science and Ethics: Can Science Help Us Make Wise Moral Judgments?
Cliccando su “Conferma” dichiari che il contenuto da te inserito è conforme alle Condizioni Generali d’Uso del Sito ed alle Linee Guida sui Contenuti Vietati. Puoi rileggere e modificare e successivamente confermare il tuo contenuto. Tra poche ore lo troverai online (in caso contrario verifica la conformità del contenuto alle policy del Sito).
Grazie per la tua recensione!
Tra poche ore la vedrai online (in caso contrario verifica la conformità del testo alle nostre linee guida). Dopo la pubblicazione per te +4 punti
Altre offerte vendute e spedite dai nostri venditori

Tutti i formati ed edizioni
Promo attive (1)
In a world confronted by conflicting moral beliefs and values, the question is often raised, "Can science help us to solve our moral problems?" Many people today believe that moral principles are derived from religion. Their critics point out that the great religions often vehemently disagree about what is good, bad, right, and wrong. On the other side of a great divide stand many who say that there are no ethical standards at all and that morality is merely a question of personal taste or cultural relativity. This volume presents a unique collection of authors who generally maintain that science can help us make wise choices and that an increase in scientific knowledge can help modify our ethical values and bring new ethical principles into social awareness. Among the thirty contributors to this volume are distinguished scientists and philosophers, including Arthur Caplan, Vern Bullough, Mario Bunge, Tom Flynn, Susan Haack, Richard Hull, Scott Lilienfeld, Ronald Lindsay, Thomas Szasz, Richard Taylor, and others. Among the wide-ranging topics discussed are bio-genetic engineering, stem cell research, organ transplants, human enhancement, abortion, euthanasia, psychiatry, and psychotherapy. Editor Paul Kurtz maintains that there is a modified form of naturalistic ethics that is directly relevant to both science and ethics and provides guidelines for our moral choices.
L'articolo è stato aggiunto al carrello
Le schede prodotto sono aggiornate in conformità al Regolamento UE 988/2023. Laddove ci fossero taluni dati non disponibili per ragioni indipendenti da IBS, vi informiamo che stiamo compiendo ogni ragionevole sforzo per inserirli. Vi invitiamo a controllare periodicamente il sito www.ibs.it per eventuali novità e aggiornamenti.
Per le vendite di prodotti da terze parti, ciascun venditore si assume la piena e diretta responsabilità per la commercializzazione del prodotto e per la sua conformità al Regolamento UE 988/2023, nonché alle normative nazionali ed europee vigenti.
Per informazioni sulla sicurezza dei prodotti, contattare productsafetyibs@feltrinelli.it
L’articolo è stato aggiunto alla lista dei desideri

